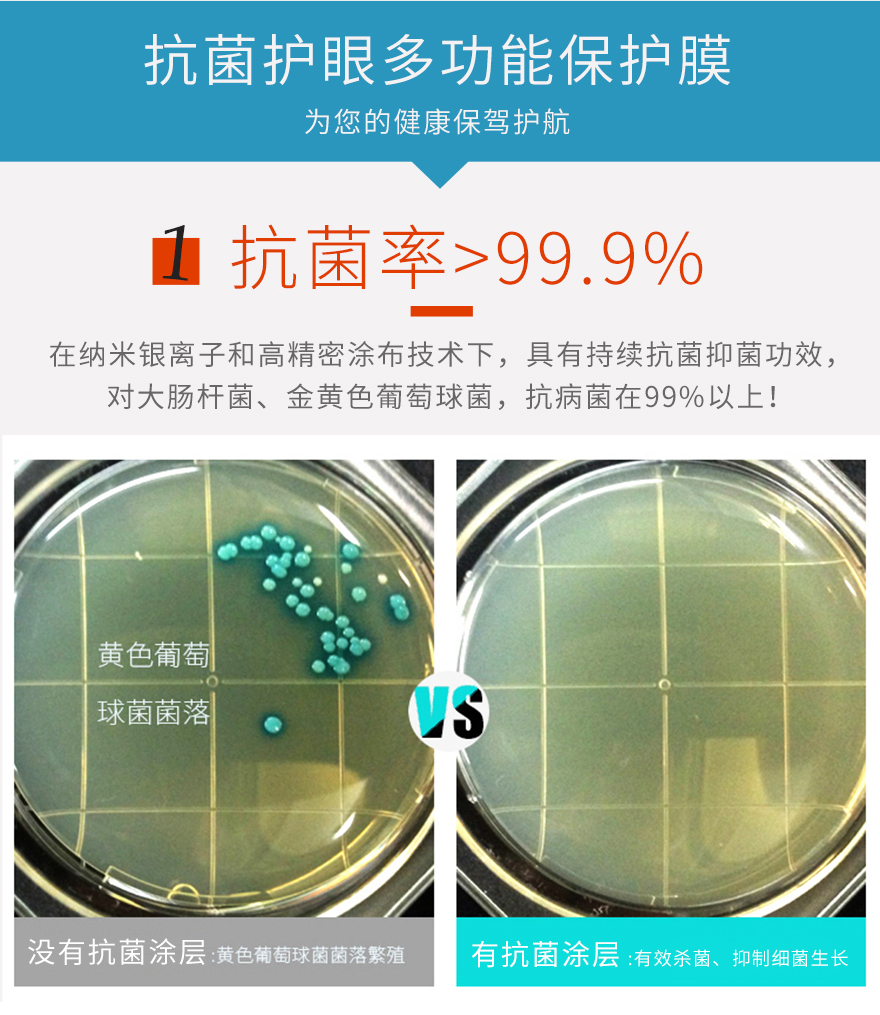

納米銀離子pet抗菌保護膜

規格參數
| 產品名稱: | pet抗菌貼膜 | 透光率: | >90% |
|---|---|---|---|
| 功能分類: | 抗菌抑菌/防藍光 | 顏色: | 高清、高透 |
| 抗菌率: | 99.9% | 藍光阻隔率: | 30% |
| 使用層厚度: | 0.15mm | 防刮性能: | 2~3H |
| 是否定製: | 按圖紙、來樣定製 | 膠層: | 矽膠 |
| 應用領域: | 可用手機、平板電腦、銀行ATM機、醫療、公共服務等智能終端顯示屏 | ||
常見問題
PET抗菌膜真的有用嗎?
PET抗菌膜原材采用日本進口,是在薄膜表麵通過納米銀離子塗層技術處理,對留在薄膜上的細菌進行包裹、吞噬,從而殺死細菌並抑製繁殖,且對大腸杆菌、金黃色葡萄球菌抗菌率在99%以上,具有持續抗菌抑菌功效!
為什麽納米銀離子能夠抗菌抑菌?抗菌貼膜的原理是什麽?
銀離子Ag+的殺菌能力特別強,每升水中隻要含億萬分之二毫克的銀離子Ag+,即可殺死水中的大部分細菌。尤其是六邊形納米銀粒子比球形和三角形納米銀粒子具有更強的抗菌性能。此外,相比市麵上較多的有機化合抗菌物質(例如季銨鹽),銀離子Ag+在對抗多重耐藥菌方麵也有明顯優勢。
抗菌貼膜除了能夠抗菌抑菌,還有哪些功能?
這款抗菌膜材料是集合多功能的保護膜,高抗菌性能和高透明性能兼備,除了一般pet保護膜具有的防刮、防指紋功能,也可以抗藍光護眼,抗UV紫外光、抗靜電。
pet抗菌膜的抗菌效果一般能維持多久?
在抗菌塗層沒有被破壞的情況下,目前使用的pet抗菌膜的抗細菌功效是具有持久性的,不建議使用酒精等溶劑擦拭表麵。
抗菌貼膜可以使用在哪些領域?
抗菌貼膜應用領域:醫院醫療顯示終端屏幕,手機/平板ipads等智能產品各類液晶顯示屏,各類實驗室,ATM和自助售票係統,食品加工場所,公用台麵及一切對環境衛生有要求的場所。
>>想了解更多產品信息可在線谘詢客服





